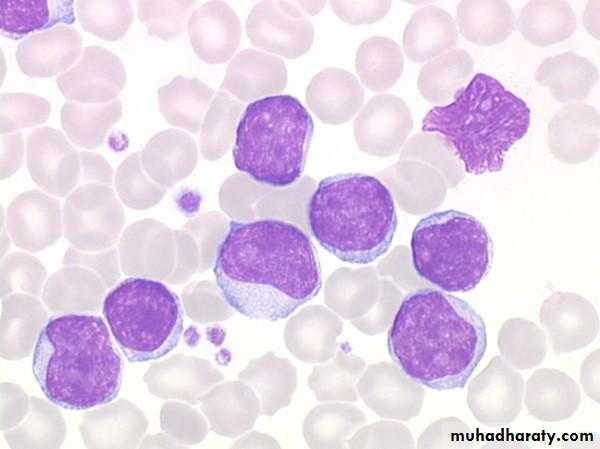

Acute leukaemia
BlastaemiaBlast cells :
Large cells
High nucleo/cytoplasmic ratio
Open immature chromatin
May contain nucleoli in the nucleus
Chronic myeloid (granulocytic) leukaemia
Marked leukocytosis
Mixture of granulocytes at different stages of maturationBasophilia
Chronic lymphocytic leukaemia
Absolute mature small lymphocytosis